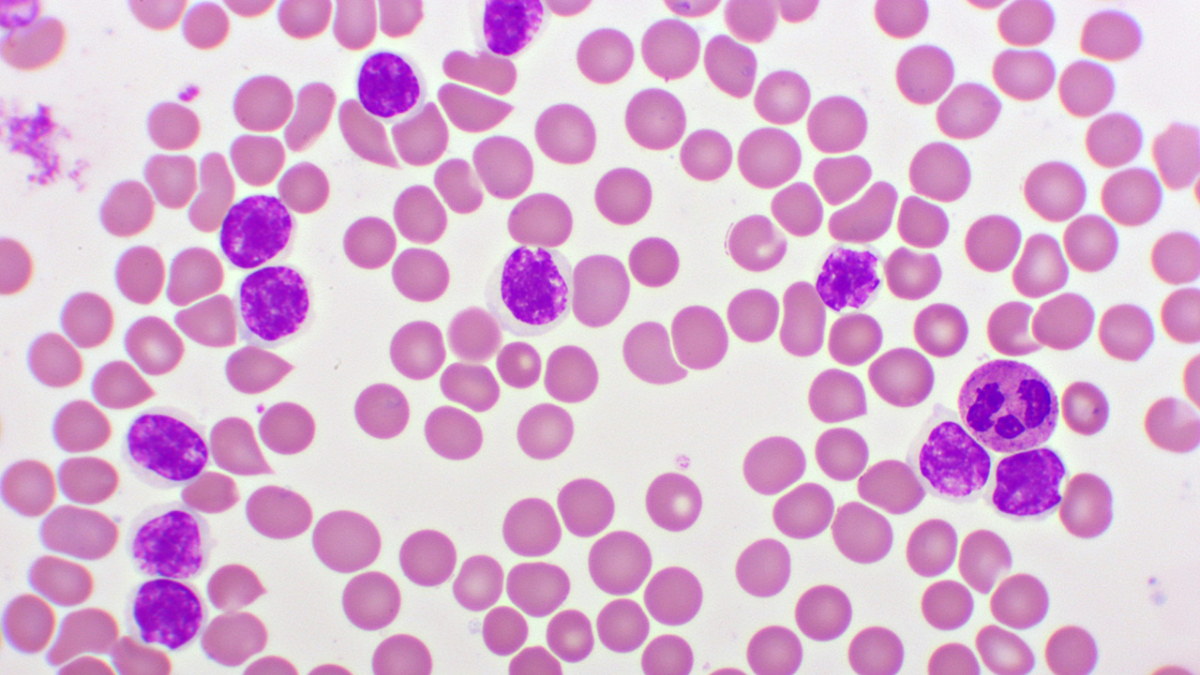
02-mehul-choksi

Fugitive diamantaire Mehul Choksi, wanted in connection with a massive bank fraud in India, is now battling a critical health condition as he faces possible extradition from Belgium. The 65-year-old, who was recently detained by Belgian authorities following an Indian extradition request, has reportedly been diagnosed with chronic lymphocytic leukemia (CLL)—a type of blood cancer that primarily affects older adults.
Cancer Diagnosis Complicates Legal Proceedings
Choksi, once a prominent figure in India’s diamond trade, has been accused of orchestrating a multi-crore loan scam involving the Punjab National Bank. After fleeing India in 2018, he has since moved between several countries, eventually settling in Antigua and Barbuda. He is now said to be living in Antwerp, Belgium, with his wife Preeti.

According to recent reports, Choksi had been planning to travel to Switzerland for treatment at a reputed cancer facility when he was taken into custody by Belgian authorities. His legal team has cited medical grounds to delay or oppose extradition, complicating the already contentious international case.
Understanding Chronic Lymphocytic Leukemia (CLL)
As per Dr Aditya Sarin, Associate Consultant, Medical Oncology, Sir Ganga Ram Hospital, Delhi, chronic lymphocytic leukemia is the most common form of leukemia in adults. It originates in the bone marrow, where white blood cells called lymphocytes are produced. In CLL, these cells become abnormal and multiply uncontrollably, crowding out healthy blood cells and impairing immune function.
Also Read: Delhi Sizzles: IMD Warns Of Scorching Heatwave As Temperatures Set To Cross 42 Degrees Celsius
Unlike acute leukemia, CLL develops slowly and can go unnoticed for years. In many cases, it is only detected through routine blood tests. While some individuals live with it without significant symptoms, others experience serious health issues requiring medical intervention.
Common Symptoms of CLL
CLL can be difficult to detect early on, as many patients are asymptomatic during the initial stages. However, as the disease progresses, certain signs may appear:
- Fatigue: One of the earliest and most persistent symptoms due to anemia caused by reduced red blood cells.
- Frequent Infections: CLL compromises the immune system, making patients more prone to recurring infections.
Also Read: WHO Unveils First-Ever Clinical Guidelines To Bolster Global Battle Against Meningitis
- Swollen Lymph Nodes: Particularly in areas like the neck, armpits, and groin.
- Night Sweats and Fever: Often without any clear underlying infection.
- Unexplained Weight Loss: A hallmark of many cancers, including CLL.
- Pain or Fullness Under the Ribs: Caused by an enlarged spleen or liver.
Who Is at Risk?
While the exact cause of CLL remains unknown, doctors have identified certain factors that increase the likelihood of developing the condition:
- Age: Most patients diagnosed are over 65.
- Gender: Men are more frequently affected than women.
- Family History: Having close relatives with CLL significantly raises the risk.
- Genetic Mutations: Abnormal changes in chromosomes are common in CLL patients.
- Chemical Exposure: Exposure to Agent Orange, a herbicide used in the Vietnam War, has been linked to an increased risk of developing CLL.
- Monoclonal B-cell Lymphocytosis: A precursor condition where people have an elevated number of identical B-cells, potentially progressing into CLL over time.
Is There a Cure?
Currently, there is no definitive cure for chronic lymphocytic leukemia, but modern treatments can manage the condition effectively and help patients live longer, healthier lives. Therapies include targeted drugs, chemotherapy, and sometimes bone marrow transplants in severe cases.
Bottomline
For patients like Mehul Choksi, managing the disease becomes especially challenging when compounded by legal troubles and international detention. As the extradition battle continues to unfold, so too does the story of his ongoing health crisis—raising complex questions about medical ethics, human rights, and the legal ramifications of serious illness in cases involving international fugitives.
Also watch this video
How we keep this article up to date:
We work with experts and keep a close eye on the latest in health and wellness. Whenever there is a new research or helpful information, we update our articles with accurate and useful advice.
Current Version